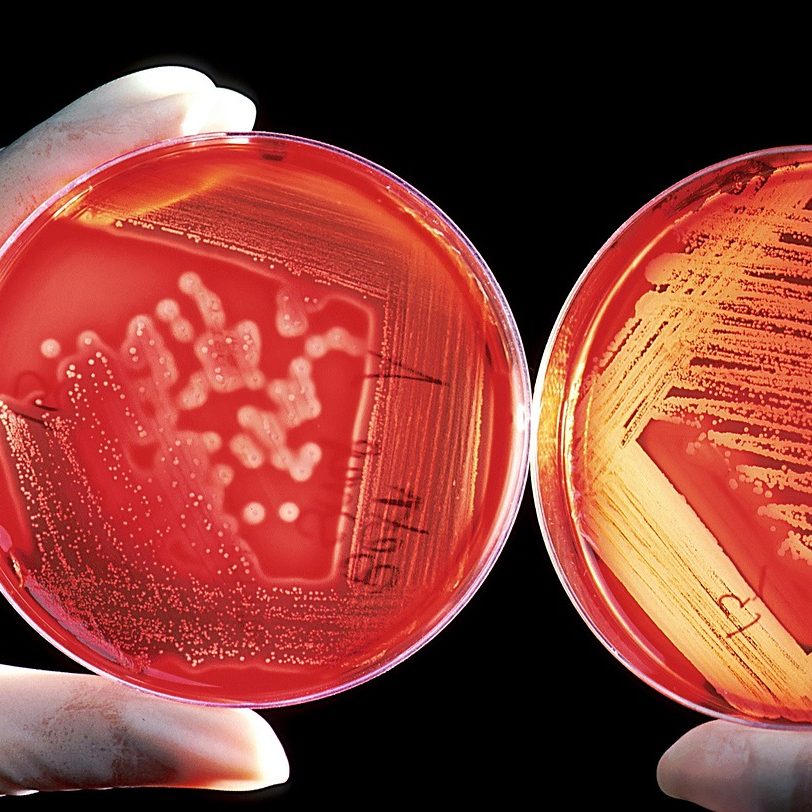

Aromatherapie zwischen Wissenschaft und Esoterik – eine ruhige Einordnung
In Kürze / Inhaltsübersicht
- Aromatherapie ist weder Humbug noch Wundermedizin.
- Sie wirkt über biochemische, neurophysiologische und psychologische Prozesse.
- Sie versteht sich als Komplementärtherapie, nicht als Ersatz für Medizin.
- Fachwissen, Qualität und korrekte Anwendung sind entscheidend für Sicherheit.
- Es gibt wissenschaftliche Evidenz – und gleichzeitig viel Hype und unseriöse Versprechen.
Aromatherapie zwischen Faszination und Skepsis
Kaum ein naturheilkundliches Feld wird so unterschiedlich wahrgenommen wie die Aromatherapie.
Für manche wirkt sie zu weich, zu emotional, zu „nicht greifbar“. Für andere wird sie zur Lösung für nahezu alles erklärt.
Zwischen diesen Polen geht häufig das verloren, worum es eigentlich geht:
eine seriöse, verantwortungsvolle Komplementärtherapie, die auf messbaren Wirkmechanismen, klinischen Daten und jahrzehntelanger Erfahrung beruht – und gleichzeitig klare Grenzen kennt.
Dieser Beitrag lädt dazu ein, Aromatherapie weder zu idealisieren noch abzuwerten, sondern einzuordnen.

Die wissenschaftliche Basis: Wie Düfte wirken
Ätherische Öle entfalten ihre Wirkung über mehrere Ebenen gleichzeitig.
1. Olfaktorischer Weg – der direkte Draht ins Gehirn
Duftmoleküle gelangen über die Riechschleimhaut direkt in das limbische System – jenen Bereich des Gehirns, der für Emotionen, Erinnerungen, Stressverarbeitung und Motivation zuständig ist.
Dieser Weg umgeht den bewussten Verstand. Deshalb reagieren Körper und Nervensystem oft schneller als Gedanken.
2. Biochemische Wirkung
Ätherische Öle bestehen aus hochkomplexen Molekülgemischen.
Viele ihrer Inhaltsstoffe zeigen hormonähnliche, entzündungshemmende, schmerzlindernde, antibakterielle, antivirale oder fungizide Eigenschaften. Diese Effekte lassen sich experimentell und reproduzierbar nachweisen.
3. Topische und pharmakologische Effekte
Über die Haut angewendet – korrekt verdünnt – wirken ätherische Öle lokal auf Gewebe, Durchblutung und Entzündungsprozesse. Auch systemische Effekte sind beschrieben und untersucht.
Klinische Daten und belegte Effekte
Die Wirkung ätherischer Öle ist längst nicht nur Erfahrungswissen. Für eine Vielzahl von Anwendungsbereichen liegen klinisch repräsentative Studien aus unterschiedlichen medizinischen Fachrichtungen vor.
Untersucht wurden sowohl körperliche als auch emotionale Prozesse. Studien beschreiben unter anderem eine unterstützende Wirkung bei der Schmerzbewältigung, bei Schlafstörungen, innerer Unruhe, Angstzuständen und depressiven Verstimmungen. Ebenso zeigen sich positive Effekte bei Übelkeit und Erbrechen, bei Atemwegserkrankungen sowie bei hormonell bedingten Beschwerden, etwa im Rahmen des menopausalen Syndroms.
Besonders gut dokumentiert ist der Einfluss ätherischer Öle auf die Lebensqualität. Sowohl in der alleinigen Anwendung als auch begleitend zu konventionellen Therapien berichten Studien über eine spürbare Entlastung und eine subjektiv verbesserte Befindlichkeit.
Therapiesicherheit – bei fachgerechter Anwendung
Ein oft übersehener Aspekt ist die Sicherheit. Bei korrekter Anwendung zeigen sich in der klinischen Erfahrung überwiegend nur milde, vorübergehende Hautreaktionen.
Deshalb gilt Aromatherapie – bei fachlicher Begleitung – auch für:
- Kinder
- ältere Menschen
- multimorbide und multimedikamentös behandelte Personen
Kontaktallergien sind grundsätzlich möglich. Ihre Häufigkeit liegt bei den meisten ätherischen Ölen unterhalb bekannter Standardallergene.
Aromatherapie beim Hund – was sich übertragen lässt und was Fachwissen braucht
Immer wieder wird argumentiert, dass es für Hunde deutlich weniger Studien zur Aromatherapie gibt als für den Menschen. Das ist richtig – und zugleich nur ein Teil der Wahrheit.
Viele grundlegende physiologische Systeme von Mensch und Hund sind nahezu identisch aufgebaut:
Blut- und Lymphsystem, Nervensystem, Hormonsystem sowie zentrale Organfunktionen unterscheiden sich in ihrer Arbeitsweise kaum. Auch die neurobiologischen Grundlagen der Duftwahrnehmung und der emotionalen Verarbeitung sind vergleichbar.
Aus diesem Grund lassen sich zahlreiche Wirkmechanismen ätherischer Öle grundsätzlich übertragen – vorausgesetzt, sie werden fachlich korrekt eingeordnet.
Genau hier beginnt die Verantwortung von Tierheilpraktikerinnen, Tiertherapeuten und ausgebildeten Aromatherapeutinnen für Hunde.

Unterschiede, die entscheidend sind
So ähnlich sich viele Systeme sind, so wichtig sind die Unterschiede.
Hunde verstoffwechseln ätherische Öle anders als Menschen. Besonders relevant sind dabei:
Leberstoffwechsel
Enzymausstattung
Körpergewicht und Oberfläche
individuelle Sensibilitäten
Auch die Verträglichkeit einzelner ätherischer Öle, die Dosierung und die Anwendungsform unterscheiden sich teils erheblich vom Menschen.
Was beim Menschen gut geeignet ist, kann beim Hund ungeeignet oder sogar belastend sein – und umgekehrt. Dieses Wissen lässt sich nicht „erschnuppern“, sondern erfordert fundierte Ausbildung.
Aromatherapie beim Hund – sinnvoll, wenn sie fachlich begleitet wird
Wird dieses Fachwissen berücksichtigt, kann Aromatherapie auch beim Hund eine wertvolle, sanfte Ergänzung sein:
zur Unterstützung bei Stress, Unruhe und emotionaler Dysbalance
begleitend bei chronischen Belastungen
zur Förderung von Wohlbefinden und Lebensqualität
Nicht als Ersatz für tierärztliche Diagnostik oder Therapie, sondern als komplementärer Baustein, eingebettet in ein ganzheitliches Konzept.
Die entscheidende Frage ist daher nicht, ob Aromatherapie beim Hund sinnvoll ist, sondern wer sie anwendet – und wie.
Die sichere Anwendung setzt fundiertes Wissen voraus – sowohl über die biochemischen Wirkmechanismen als auch über die besonderen physiologischen Anforderungen des Hundes.
Wo Aromatherapie kritisch betrachtet werden sollte
Die größten Probleme entstehen nicht durch die Aromatherapie selbst, sondern durch ihren Umgang.
Kein Ersatz für medizinische Behandlung
Aromatherapie begleitet. Sie ergänzt.
Sie ersetzt keine Diagnostik, keine Medikamente und keine medizinische Therapie bei ernsthaften Erkrankungen.
Überzogene Versprechen
Vor allem im Umfeld mancher MLM-Strukturen werden Wirkungen versprochen, die wissenschaftlich nicht haltbar sind. Solche Aussagen schaden dem gesamten Fachgebiet.
Risiken bei falscher Anwendung
Unverdünnte Anwendung, falsche Dosierungen oder ungeeignete Öle können Hautreizungen, Sensibilisierungen oder Organschäden begünstigen – insbesondere bei empfindlichen Menschen und Tieren.
Qualität ist entscheidend
Nicht jedes Öl, das gut riecht, ist therapeutisch geeignet. Herkunft, Gewinnung, chemisches Profil und Lagerung beeinflussen Wirkung und Sicherheit erheblich.

Fazit: Ein Feld mit Tiefe – und Verantwortung
Aromatherapie ist weder Magie noch Mythos.
Sie ist ein ernstzunehmendes, gut untersuchtes Feld mit großem Potenzial für Wohlbefinden und Lebensqualität – wenn sie fachlich fundiert, verantwortungsvoll und ergänzend eingesetzt wird.
Qualifizierte Begleitung, hochwertige Produkte und ein realistischer Blick auf Möglichkeiten und Grenzen schaffen Vertrauen.
Skepsis gegenüber Heilsversprechen schützt – Offenheit gegenüber belegten Wirkungen bereichert.
Vielleicht liegt genau hier ihre größte Stärke:
nicht im Lauten, sondern im Wirksamen.
